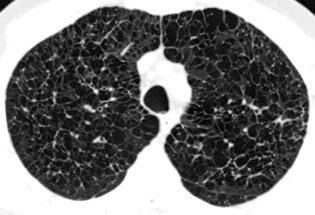

TÓRAX. SIGNOS Y PATRONES RADIOLÓGICOS. VI.DIAFRAGMA.

Revisado y modificado
18-7-2024



Dr. César Pedrosa Madrid

![]()


Revisado y modificado
18-7-2024



Dr. César Pedrosa Madrid

2. ÍNDICE
3. DIAFRAGMA ANATOMÍA
5. ANATOMÍA. CRURAS DIAFRAGMÁTICAS
6. ANATOMÍA. NERVIO FRÉNICO

*En el modo “Presentación” se puede acceder a cada signo con un click sobre el nombre *Algunos signos tienen más de una diapositiva *Esquina superior derecha
”Retorno al índice”
7. DIAFRAGMA DERECHO. ANATOMÍA
8. DIAFRAGMA DERECHO. BORRAMIENTO DEL 9. ANATOMÍA. DIAFRAGMA IZQUIERDO.
10. DIAFRAGMA IZQUIERDO. BORRAMIENTO
11. DIAFRAGMA DERECHO. DATOS ANATÓMICOS

12. DIAFRAGMA DERECHO. GRASA PERICAVAL
13. DIAFRAGMA. FUNCIÓN
14. DIAFRAGMA PLANO
15. . DIAFRAGMA CONTNUO, SIGNO DEL
16. DOBLE DIAFRAGMA, SIGNO DEL
17. ELEVACIÓN DIAFRAGMÁTICA BILATERAL
18. ELEVACIÓN BILATERAL. ENF. DE CHAGAS
19. SILENCIO SUBDIAFRAGMÁTICO, SIGNO DEL
21. ELEVACIÓN BILATERAL DE CAUSA PULMONAR
22. ELEVACIÓN BILATERAL. SÍNDR. ANTISINTETASA
23. ELEVACIÓN DIAFRAGMÁTICA UNILATERAL. CAUSAS
25. ELEVACIÓN UNILATERAL. TEP
26. ELEVACIÓN UNILATERAL + ATELECTASIA CRÓNICA
27. ELEVACIÓN UNILATERAL DE CAUSA ABDOMINAL
28. ELEVACIÓN UNILATERAL. OBSTRUCCIÓN INTESTINAL
29. FALSA ELEVACIÓN DIAFRAGMÁTICA. GRASA
31. ENFERMEDAD TORACOABDOMINAL. TUMOR
33. ENF. TORACOABDOMINAL. SEUDOQUISTE PANCREÁTICO


34. ENF. TORACOABDOMINAL. ANEURISMA INTRACRURAL
35. ENF. TORACOABDOMINAL. QUISTE HIDATÍDICO
36. ENF. TORACOABDOMINAL. ÁREA DESNUDA
37. ESPLENOSIS TORÁCICA
38. EVENTRACIÓN DIAFRAGMÁTICA
39. EVENTRACIÓN IZQUIERDA
40. EVENTRACION DIAFRAGMÁTICA FOCAL.
41. EVENTRACIÓN FOCAL CON ASCITIS
42. HERNIA DE BOCHDALEK
42. GANGLIOS DIAFRAGMÁTICOS
43. HERNIA DE BOCHDALEK . “RIÑÓN INTRATORÁCICO
44. HERNIA HIATAL
45. HERNIA DE MORGAGNI
46. HERNIA PARAESOFÁGICA
47. INTERPOSICIÓN CÓLICA DE CHILAIDITI
48. INVASIÓN DIRECTA DE CRURA DIAFRAGMÁTICA
49. INVERSIÓN DIAFRAGMÁTIC. MESOTELIOMA

51. METÁSTASIS DIAFRAGMÁTICAS
52. PARÁLISIS FRÉNICA
53. PARÁLISIS FRÉNICA TRANSITORIA
54. QUISTE HIDATÍDICO DIAFRAGMÁTICO
56. ROTURA DIAFRAGMÁTICA. TRAUMA
58. ROTURA DIAFRAGMÁTICA. DIAFRAGMA COLGANTE, SIGNO DEL
60. ROTURA DIAFRAGMÁTICA RETRASADA
61. TUMOR FIBROSO DE PLEURA DIAFRAGMÁTICA

Hoja fibromuscular que separa las cavidades torácica y abdominal





Externa muscular

Okuda I et al. Diaphragm and related Lesions on chest radiographs. RSNA. 2018
Nason L K et al. Imaging of the diaphragm: anatomy and function. Radiographics 2012.

Parte lumbar: 1.Ligamentos arcuatos medial y lateral






2. Cruras conectadas a vértebras lumbares y discos. L1-3 a la dcha. L1-2 a la izda.




Cruras conectadas por encima del tronco celíaco por ligamento fibroso arcuato medial. Panicek DM et al. Radiographics. 1998










Las fibras más bajas de las cruras se funden con las de las vainas de los músculos psoas, acotando un espacio llamado “Espacio abierto de la vaina del psoas”, que comunica las cavidades torácica y abdominal.
Panda A et al. “Straddling Across Boundaries”. Thoracoabdominal Lesions: Spectrum and Pattern Approach. Curr Probl Diagn Radiol, 2015 /Restrepo CS et al. The diaphragmatic crura and retrocrural space: normal imaging appearance, variants, and pathologic conditions. Radiographics 2008

Entra al tórax posterior al TBVI. Desciende lateral al arco aórtico, aurícula izquierda y VI.

N. frénico izdo.

N. frénico dcho.




















Visible en toda su longitud en ambos planos. Excepción: Parte medial en PA.

Borramiento del hemidiafragma derecho







“Visible en toda su longitud en lateral”.





Consolidación por Infarto pulmonar. (TEP)








Visible en 2/3 posteriores
El corazón borra el1/3 anterior



Hemidiafragma izquierdo Atelectasia de la pirámide basal izquierda borrando la parte medial y posterior.











Diafragma derecho





Borde posterior de Vena cava superior
Visible: 10-20%




Diafragma izquierdo +/-16mm El ligamento pulmonar izquierdo (LPI) puede interrumpir la interfase normal pulmonar-diafragma obliterando un pequeño segmento
Proto AV,. The left lateral radiograph of the chest. Part One. Med. Radiogr. Photogr.1979.



Variante: Aire/grasa por delante de la VCI







Proto AV,. The left lateral radiograph of the chest. Part One. Med. Radiogr. Photogr.1979.
Molinari F et al. Fat-containing Lesions in adult thoracic imaging. AJR.2011











Excursión diafragmática: 0,8-8cm Derecho mas alto (2-3 cm) 89% (Felson)
Nason LK. Imaging of the diaphragm: anatomy and function. Radiographics 2012

El diafragma tiende a estar más plano:
1º. Con la vejez, 2º. Con mayor peso.
3º. Con dimensiones torácicas anchas Suwatanapongched. Chest 2003

Magnetic resonance analysis of abnormal diaphragmatic motion in patients with emphysema
T Iwasa. Eur Respir. 2002




“Enfisema”



Visualización del diafragma, incluso en la parte central, debido al neumomediastino











Neumonía intersticial usual. Neumomediastino. Enfisema subcutáneo
Zylak CM et al. Pneumomediastinum Revisited. Radiographics 2000



El aire en la cavidad pleural, neumotórax, queda en ocasiones atrapado en la base pulmonar, siendo difícil el diagnóstico diferencial con neumomediastino.





Anorexia nerviosa, Tuberculosis masiva izquierda con neumotórax y cavidades. Diseminación broncógena derecha con cavitación. M. complex
ZylakCM et al. Pneumomediastinum Revisited.Radiographics 2000





Causas anormales
Ascitis. Masa abdominal
Hepatoesplenomegalia
Riñones poliquísticos
Distensión abdominal.
Reeder-Felson. Gamuts in Radiology.2017






Hepatomegalia metastática. Ca. de pulmón
C. Parálisis frénica bilateral
Suryanarayana J et al Difficult to wean: think of the diaphragm. BMJ Case Rep.. 2014.







Hochberg NS et al. Chagas Disease. Ann Intern Med. 2023




¡SILENCIO SUBDIAFRAGMÁTICO!
En el normal, el espacio subdiafragmático siempre tiene algo de gas.

También es visible la grasa del canal parietocólico.



Normal


Causas del “silencio”
Hepatoesplenomegalia
Riñones poliquísticos
Ascitis masiva
Carcinomatosis peritoneal



Elevación bilateral por riñones poliquísticos. Hernia hiatal ¡Sin gas en abdomen!


Hernia de Morgagni con asas.

En el normal, el espacio subdiafragmático siempre tiene algo de gas. También es visible la grasa del canal parietocólico.

Hepatoesplenomegalia en Hematopoyesis extramedular. Borramiento de la grasa del canal parietocólico









Delavaud G et al. Paravertebral extramedullary Hematopoiesis. Diagnostic and Interventional Imaging. 2014.




1. < Volumen pulmonar
Fibrosis intersticial
Asbestosis

Sarcoidosis


Fibrosis pulmonar


Neumonitis de hipersensibilidad
Sind. antisintetasa
2.Atelectasia bilateral
3. Enf. neuromuscular
Rajan SK et al. Progressive pulmonary fibrosis: an expert groupconsensus statement. Eur Respir J 2023;


Nason LK. Imaging of the diaphragm: anatomy and function. Radiographics 2012




< Volumen pulmonar
Síndrome antisintetasa
(Miositis anti Jo-1).
Artralgias migratorias, Miositis, “Manos de mecánico”, Raynaud y Enfermedad
intersticial pulmonar (>70%).
Waseda Y et al.. Eur J Radiol. 2016
A. Causas fisiológicas

Respiración superficial (la más frecuente)
Obesidad/Embarazo
B. Fibrosis pulmonar

















Resección pulmonar.
Los vasos aparecen paralelos en el lado derecho.







Dandawat.N et al. Diaphragmatic paralysis in COVID-19: a rare cause of postacute sequelae of COVID-19 dyspnoea . MJ

Tromboembolismo pulmonar Diafragma elevado 20%














Atelectasia crónica de LLI en paciente con enfermedad neuromuscular.







. Enfermedad abdominal
1.Absceso subfrénico





2. Estómago distendido
3. Interposición cólica
4. Masa. hepática/esplénica
E. Hernia diafragmática

F. Eventración diafragmática
G.Rotura traumática
H. Tumor diafragmático



Absceso subfrénico, E. Coli Colección drenada por ecografía.













¿Asociación con cirrosis?.
Ghonge NP. Hepatodiaphragmatic fat interposition' and 'increased right hemidiaphragmatic thickness': new imaging signs for early diagnosis of hepatic cirrhosis on routine CT abdomen. Abdom Radiol 2020.









Grasa simulando elevación diafragmática izquierda













Espondilitis infecciosa . (esp. Tb)
Seudoquiste pancreático
Tumores diseminados (especialmente testículo)
T. de cél ganglionares
Linfoma

Carcinoma broncogénico (esp. microcítico)
Hematopoyesis extramedular



T. mixto de células germinales del testículo izquierdo


Nódulos pulmonares múltiples. (flechas verdes). Masas paratraqueales. (flechas amarillas). Dudoso ensanchamiento retrocrural (flechas negras). sigue….
Ttawfik A et al. Trans-diaphragmatic Pathologies: Anatomical Background and Spread of Disease on cross-sectional Imaging. Current Problems in Diagnostic Radiology. 2021.



T. mixto de células germinales del testículo








izquierdo Metástasis pulmonares. (flechas verdes). Ganglios paratraqueales. (flechas amarillas). Ganglios retroperitoneales (flechas negras)

Tawfik A et al. Trans-diaphragmatic Pathologies: Anatomical Background and Spread of Disease on cross-sectional Imaging. Current Problems in Diagnostic Radiology. 2021.





3 rasgos: Conexión entre mediastino y lesión pancreática. Derrame pleural Hallazgos de pancreatitis. Matsusue E et al.Three cases of mediastinal pancreatic pseudocysts. Acta Radiol Open. 2016 .










Aneurisma aórtico intracrural











/Restrepo CS et al. The diaphragmatic crura and retrocrural space: normal imaging appearance, variants, and pathologic conditions. Radiographics 2008
Dr. César Pedrosa












Quiste hidatídico pulmonar (¿implante cisural?) y hepático ¿perforado al espacio pleural?
M et al. Thoracic hydatid disease: A radiologic review of unusual cases. World J Clin Cases 2020


A et al. “Straddling Across Boundaries”. Thoracoabdominal Lesions: Spectrum and Pattern Approach. Curr Probl
Área desnuda. El hígado en contacto directo con el tendón central del diafragma.
Contiene el hiato de VCI.

Comunica con el hiato esofágico y el espacio pararrenal anterior.

Colecciones “inflamatorias” abdominales llegan al tórax vía el hiato esofágico o por vía transdiafragmática








Quiste hidatídico hepático calcificado y pulmonar. Atelectasia LID asociada

Autotrasplante de tejido esplénico al tórax tras trauma. (T. Penetrante más frecuente que cerrado)

Causas:
1. Trauma 2.Esplenectomía
3. Diseminación hematógena
4. ¿Hipoxia?

T1: Hipointenso
T2: Hiperintenso. Puede ser hipointenso. (Hierro)
Esplenectomía previa


Ferrer TM et al. Thoracic splenosis: History is the key. Respiratory Medicine Case Reports. 2017







Parte muscular del diafragma congénitamente delgada que permite la protrusión del contenido abdominal hacia el tórax.
Parece aumentar con la edad.






Derecha/izquierda 5:1
En la derecha, “relajación” antero-medial



Heiwegen K et al. Congenital diaphragmatic eventration and hernia sac compared to CDH with true defects: a retrospective cohort study. Eur J Pediatr. 2020






Elevación marcada de hemidiafragma izquierdo por "eventración". En cirugía, ausencia de la parte muscular del diafragma










Nattusamy L et al.
Focal eventration of diaphragm with fat content. BMJ Case Rep. 2014.









Eventración localizada con ascitis









Nattusamy L et al. Focal eventration of diaphragm with fat content. BMJ Case Rep. 2014.
Linfoma de amigdala tratado diez años antes
Linfoma de Hodgkin..10
Linfoma no Hodgkin…2

Carcinoma.................... 7

Visualización en 21 casos
Positivo................6 (35%)
Dudoso.................3

Negativo..............8 (47%)
Vock. 1986.
(1 Burkitt-1 Indiferenciado)


Supradiafragmático......3 mama, pulmón, carcinoide tímico
Infradiafragmático........4
Ovario… ………………..3
Carcinomatosis peritoneal1








Saco: <5%.
90% de las hernias congénitas
Lado izdo.:.80%
Lado derecho: 15%.
Bilateral 5%.
13138 estudios de Tc.
Incidencia 0,17%.
Mullins ME, Saini S. Imaging of incidental Bochdalek hernia.
Semin Ultrasound CT MR. 2005

Puede contener: Intestino, Bazo, Riñón, Páncreas, Hígado (Lób. Izdo.)









Saco: <5%.

Puede contener: Intestino, Bazo, Riñón, Páncreas, Hígado (Lób. Izdo.)









Navaratnarajah A, et al. Bochdalek hernias associated with intrathoracic kidney: a case report and systematic review of outcomesincluding renal function. Clin Nephrol Case Stud 2020/Sandstrom CK. Diaphragmatic Hernias: A Spectrum ofRadiographic Appearance Curr Probl Diagn Radiol, 2011



del hiato esofágico que permite la subida al tórax de estómago y omento.
(Excepcionalment e otras áreas)

TC: 5% de individuos < de 40 años.
30% de los de 40-49 años
65% de los de 60-79 años







Masa retrocardiaca, habitualmente asintomática. Puede tener nivel hidro-aéreo Muller-Silva. High-yield Imaging. Saunders 2010


Defecto anteromedial
(Espacio de Larrey)

Desarrollo anómalo del septum trasversum.
Rara: 2-3% de las hernias. > en lado derecho. (Corazón protege) Mujeres, edad media. Órganos afectados: Hígado, intestino, mesenterio
Asociada a obesidad, trauma, levantamiento de pesos u otras causas de
> Pres. Abd..

Bianchi E et al. Journal of Medical Case Reports 2013










H. Paraesofágica. Raramente asintomática. Disfagia, dolor torácico, reflujo etc.

Complicaciones
Incarceración de órganos abdominales, perforación y vólvulo gástrico.






Sihvo EI et al. Fatal complications of adult paraesophageal hernia: a population-based study. J Thorac Cardiovasc Surg 2009

Cortesía. Dr. I. Pedrosa





Asociaciones:
Interposición del colon entre hígado y diafragma
Más frecuente en pacientes con EPOC, cirrosis y ascitis


Incidencia.0,025%-0,28%.
Shinha T. Chilaiditi Syndrome. Intern Med. 2017






Vólvulo de flexura esplénica. Havenstrite KA. 1999
Hernia interna de colon transverso .hite JJ. 2002
Obstrucción cólica
Basile EJ et al. Chilaiditi Syndrome Presenting as Partial Colonic Obstruction. Cureus 2020














La ocupación del espacio pleural por derrame (o obstrucción aérea) se acomoda con expansión aumentada de la caja torácica, especialmente en eje vertical. La consecuencia es aplanamiento e incluso inversión diafragmática.






Afzal S, Fatima K, Ambareen M. Antenatal ultrasound diagnosis of congenital high airway obstruction syndrome: a case report and review of literature. Cureus. 2019. Thoma R et al. Physiology of breathlessness associated with pleural effusions. Curr Opin Pulm Med. 2015

Wang JS et al. Changes in pulmonary mechanics and gas exchange after thoracentesis on patients with inversion of a hemidiaphragm secondary to large pleural effusion . Chest 1995
Mesotelioma epitelioide
Postmortem. 318 pacientes.


Diseminación extratorácica. 55,4%
Hígado. 31,9%
Bazo. 10.8%
Tiroides. 6,9%
Cerebro. 3%.
“Enfermedad Intersticial pulmonar” 0,6%







Kato K. et al. HRCT Findings of Asbestosis Revisited; Radiologic and Pathologic Correlations. Exhibit. RSNA 2012/ / Karpathiou G et al. Pleural neoplastic pathology. Respiratory Medicine 2015


Schwartz E.E., Diaphragmatic and paradiaphragmatic tumors and pseudotumors, J.Thorac.Imaging.




1989; 4: 19 -28, Zhao L et al. Isolated diaphragmatic metastasis from periosteal osteosarcoma of the humerus: a case report. Journal of Cardiothoracic Surgery .2020









Parálisis frénica
1. Ca. de pulmón

2. Tumor mediastínico maligno. P. ej.: timoma
3. Ganglios mediastínicos
4. Tuberculosis
5. Iatrogénica (post-cirugía cardiaca)
6. Idiopática









MAbbey-Mensah,GN et al. Diaphragm Appearance: A Clue to the Diagnosis of Pulmonary and Extrapulmonary Pathology. Current Problems in Diagnostic Radiology. 2017






Parálisis frénica transitoria tras cirugía de válvula aórtica




Parálisis frénica transitoria post cirugía cardiaca (10%).
Puede acompañarse de atelectasia del LII.
Benjamin JJ et al. . Left lower lobe atelectasis and consolidation following cardiac surgery: the effect of topical cooling on the phrenic nerve. Radiology 1982

Rotura al tórax. (Área desnuda del hígado)
Quistes del diafragma













0,4% de casos de trauma. 80% lado izquierdo. Bilateral. 3%

Penetrante..63% 20-59%. Arma de fuego 15-32%. Arma blanca
Trauma cerrado. 37%
Tráfico Caída de gran altura
Aplastamiento toracoabdominal

Furak J et al. Diaphragm and transdiaphragmatic injuries. J Thorac Dis 2019
Accidente de tráfico








Rx: Niveles hidroaéreos en hemitórax izquierdo Desviación mediastínica Ausencia de intestino en abdomen. Configuración en reloj de arena del intestino herniado “Tubo nasogástrico”



Furak J et al. Diaphragm and transdiaphragmatic injuries. J Thorac Dis 2019






5% de las hernias diafragmáticas
Sólo 28-64% de los casos van a cirugía porque la radiografía inicial sea diagnostica o sugerente

Trauma cerrado (5-50%)
> Presión intraabdominal
Tráfico
Caída desde altura

Trauma penetrante . (50%)
Puñalada
Proyectil
Shackelton. Radiograhics.1998

Recibe una puñalada en costado izquierdo
La laceración tiende a ocurrir en la unión

músculotendinosa . (64-90% en el lado izquierdo)


Diafragma “colgante” (“dangling sign”)


(“Dangling sign”)


TC. Mejor con multicorte. (reconstrucciones).
Asociación: Aire en pared.
Fracturas costal .Rotura esplénica. Neumoperitoneo.

Diafragma discontinúo Herniación de la grasa omental
Desser TS et al.The dangling diaphragm sign: sensitivity and comparison with existing CT signs of blunt traumatic diaphragmatic rupture. Emerg Radiol 2010






Lado derecho: 20% de las roturas retrasadas
Hallazgos en RM .
Buena en casos dudosos

Cortes sagitales y coronales: Interrupción de la línea diafragmática


Paciente que ingresa con síntomas de colecistitis aguda. Antecedentes de trauma importante muchos años antes
Zhao L et al. Delayed traumatic diaphragmatic rupture: diagnosis and surgical treatment. © Journal of Thoracic Disease.
J Thorac Dis 2021


Asas

Líquido pericolecistítico
V. biliar con cálculos



Diafragma
Líquido pericolecistítico



Pedículo vascular: 30-50%.
Tumores pleurales primitivos…<5% Tumores grandes: desplazamiento de estructuras.


RX. Masa bien definida (mejor en lateral en 33% de los casos). Localizado en cisuras o superficies pleurales. (regiones declive).
Pueden variar en posición con posición o respiración)







Rosado de Christenson M et al. From the archives of the AFIP: Localized fibrous tumor of the pleura Radiographics 2003. /Aribas
Giant Localized Solitary Fibrous Tumors of the Diaphragmatic Pleura: Report of Two Cases. Surg Today.2002.
